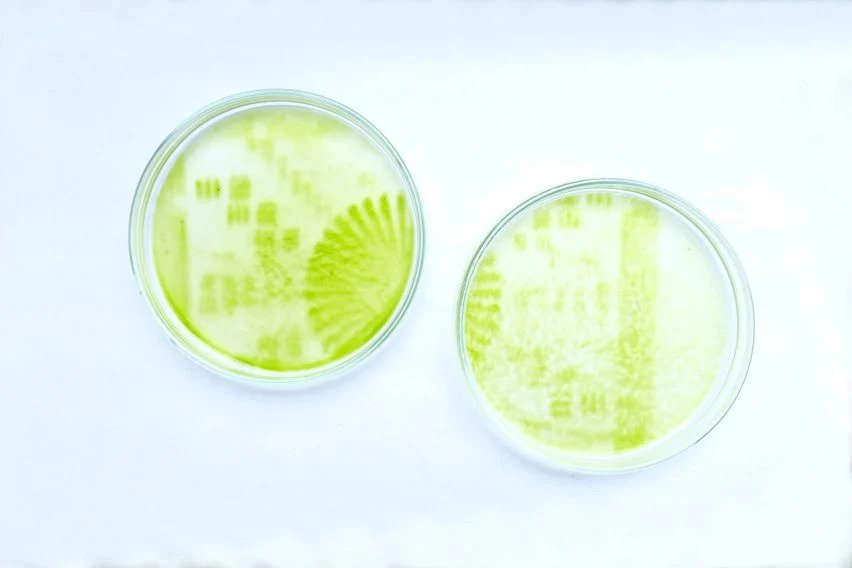
Luis Undritz

Industrial designer Luis Undritz has created an innovative printer fitted with a digital light processing laser projector that shines light onto algae to produce intricate images.
How exactly does the printer work? The first step is to send a digital negative black and white picture to the printer which then projects the image onto a surface lined with water, nutrients and microscopic marine algae. After roughly seven days of the algae growing under the light, a detailed image is conceived.
Undritz says that the inspiration behind the project came from testing how algae reacted to light during his time at Central Saint Martins art school in London. Influence also comes from screen printing, a technique commonly used to print on t-shirts.
Unfortunately, Undritz’s printer is not a suitable alternative to screen printing. This is due to the fact that fabric printed with algae is prone to water damage. Instead, the printer emulates slow fashion practices and offers something that is temporary and appreciated during its short lifespan.
All images in this article are courtesy of Luis Undritz.